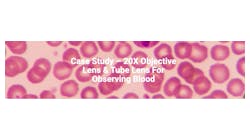

Microscope objectives
Categories
Categories
BUYER'S GUIDE LISTING INFORMATION
BUYER'S GUIDE LISTING INFORMATION
Click here for listing information and directions on how to add or update your company.
Featured Companies
Featured Companies
Featured Content
Featured Content
Latest Content
Latest Content